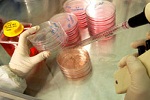
Стволовые клетки перевернут трансплантологию, заявляют эксперты

28.06.2011
Залежи старых компьютеров и телефонов вызывают рак
Так называемые электронные отходы, представляющие собой груду устаревших компьютеров, принтеров, мониторов, телефонов, негативно влияют на здоровье человека, вызывая воспаление, окислительный стресс. Все это может вылиться в сердечно-сосудистые недуги, повреждение ДНК и даже рак, сообщает The Times of India.
28.06.2011
Ученые определили, почему рак не так просто убить
Группа ученых под руководством Дэвида Литчфилда из Университета Западного Онтарио открыла механизм, позволяющий раковым клеткам становиться невосприимчивыми к лекарствам, пишет The Times of India.
28.06.2011
Одноразовая посуда может вызвать рак, предупреждают эксперты
Беременные женщины и дети, впрочем, как и остальные, должны избегать одноразовой посуды из пенопласта. С таким официальным заявлением выступило Министерство здравоохранения США, сообщает "NEWSru Israel".
28.06.2011
Исследователи научились отключать у рака механизм восстановления
Чудодейственное средство от рака груди можно превратить в универсальное оружие против опухолей, заявляют британские ученые из Университета Ньюкасла. Помимо универсальности, исследователи обещают свести к минимуму побочные эффекты вроде тошноты и усталости, сообщает The Daily Mail.
27.06.2011
Картина Пикассо поможет ученым в исследовании диабета и других болезней
"Спящая девушка" (Jeune Fille Endormie) авторства Пабло Пикассо стала источником новых возможностей для австралийских исследователей. Полотно мастера, подаренное Сиднейскому Университету неизвестным американским донором, накануне было продано на аукционе Christie's в Лондоне за 13,5 миллионов фунтов (почти 22 миллиона долларов), передает The Associated Press.
27.06.2011
Найдена чудо-смесь, позволяющая забыть о сердечной недостаточности
Соединение пикногенола и коэнзима Q10 может сделать сердечников более энергичными, укрепив их сердце, увеличив объем крови, прокачиваемый с каждым ударом, стабилизировав давление, частоту сердцебиения и дыхания, согласно последнему изысканию, опубликованному в Panminerva Medica, пишет The Times of India.
27.06.2011
Женщины вдвое менее стрессоустойчивы, чем мужчины
Женщины вдвое больше подвержены стрессу, чем мужчины, показало новое исследование. Дело в том, что слабый пол более чувствителен к гормону, который вырабатывается в организме во время сильных волнений.
27.06.2011
Чувство тревоги может помешать женщине забеременеть
Высокий уровень тревоги может навредить естественной способности женщин к зачатию. Ученые предупреждают: те женщины, которые много беспокоятся, имеют на 12% меньше шансов забеременеть, чем те, кто уравновешен. Хотя снижение шансов на успех небольшое, эксперты утверждают, что это может иметь большое значение для взрослых женщин, чьи способности к зачатию и так снижены в силу возраста.
27.06.2011
Теплые отношения с любимым человеком защитят от предродовой депрессии
Беременные женщины, которых все устраивает в отношениях, меньше рискуют пострадать от предродовой депрессии, установили норвежские ученые. Соответствующее изыскание опубликовано в журнале BMC Public Health, сообщает The Toronto Sun.
27.06.2011
Любители коллекционирования ставят свою психику под удар
Ученые из Университета Гранады заносят коллекционирование в список занятий, способных спровоцировать психическое расстройство. По их мнению, неважно, что человек собирает. Это могут быть марки, фарфоровые куклы, украшения или произведения искусства, отмечает АМИ-ТАСС.
27.06.2011
Болезни человека зависят от его характера, показали исследования
Характер человека может многое сказать о его здоровье. По мнению доктора Мартина Хаггера, психолога из Университета Ноттингема и Университета Катрина, характер является результатом работы генов и окружающей среды. Поэтому данная позиция вполне оправдана, сообщает The Daily Mail.
27.06.2011
Хронические неинфекционные заболевания - "самый страшный убийца" в мире
Хронические заболевания, такие как болезни сердца, рак и диабет, являются ведущей причиной смертности во всем мире. Такие данные содержатся в докладе, обнародованном Всемирной организации здравоохранения (ВОЗ) в среду.
27.06.2011
Диабет стремительно захватывает мир, говорит статистика
С 1980 года количество взрослых людей, больных диабетом в мире, увеличилось в два раза, показало исследование, опубликованное на страницах журнала Lancet. К такому неутешительному выводу пришли ученые из Королевского колледжа Лондона и Гарвардского университета.
27.06.2011
В Санкт-Петербурге приступили к биоиспытаниям фуллеренов - перспективной основы новейших медпрепаратов
В Санкт-Петербургских государственном университете приступили к биоиспытаниям так называемых фуллеренов, которые могут стать "основой для целой группы новых медицинских препаратов", сообщает агентство ИТАР-ТАСС.
27.06.2011
Ученые используют необычные свойства воды для доставки лекарств
Вода себя начинает странно вести, когда ее заключают в тесные пространства. Компьютерное моделирование поведения пара в углеродных нанотрубках показало: данные свойства воды можно использовать для доставки лекарств, пишет New Scientist.
27.06.2011
Стволовые клетки перевернут трансплантологию, заявляют эксперты
Уникальную технологию "тканевых биоконструкторов" разработали ученых томских вузов, СО РАН и Рижского технического университета, сообщает "Интерфакс". Данные биоконструкторы по своей структуре похожи на ткани человека. Именно это позволяет их использовать для сращивания отдельных частей тела и органов с имплантатами.
25.06.2011
Доказано: противовоспалительные средства провоцируют диабет
Мало кто знает, однако ряд препаратов приводит к развитию диабет 2 типа. Издание The Daily Mail приводит следующую историю: Тони Мартину прописали новые лекарства от астмы и полипов в носу. Вместо ожидаемого облегчения, состояние человека ухудшилось. Все прописанные средства относились к группе глюкокортикоидов – типа стероидов.
25.06.2011
Знакомые всем лекарства могут вызвать смерть пожилых людей
Сотни тысяч пожилых людей, принимающих широко распространенные препараты, на самом деле, рискуют своим здоровьем. Как показали исследования, лекарства способны повысить риск развития слабоумия и внезапной смерти, пишет The Independent.
25.06.2011
Диета пещерных людей - ключ к стройности и здоровью
В США группа экспертов опубликовала отчет, в котором оценила самые популярные диеты. Ни одна оценка не вызвала такой волны несогласия, как оценка "Палеолитической диеты". Итак, эксперты оказались не очень высокого мнения о ней. В свою же очередь, независимые ученые защищают данную методику питания, сообщает ABC News.
25.06.2011
В Красноярске открывается самый крупный в Сибире центра сердечно- сосудистой хирургии
В Красноярске свои двери открыл крупнейший в Сибири федеральный центр сердечно- сосудистой хирургии. Он состоит из четырех хирургических отделений, детской, взрослой поликлиник. Одновременно в нем могут находиться 167 пациентов (150 взрослых и 17 детей). В основном центр будет рассчитан на жителей Красноярского края, Хакасии, Алтайского края, Тувы, сообщает ИТАР-ТАСС.